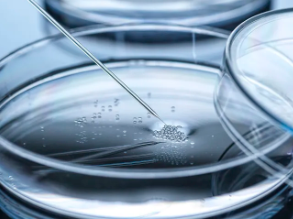
image.png

自己的干細(xì)胞抗衰老要幾針才有效,效果能維持多久
2024-11-29 15:00:52 來源: 小編 咨詢醫(yī)生
隨著科技的不斷進(jìn)步,干細(xì)胞技術(shù)在抗衰老領(lǐng)域的應(yīng)用越來越廣泛。許多人希望通過自己的干細(xì)胞來延緩衰老,那么,究竟要打幾針才能看到效果,這些效果又能維持多久呢?本文將從專業(yè)角度為您解答這些問題。
一、干細(xì)胞抗衰老的原理
干細(xì)胞抗衰老的原理在于,通過提取自身的干細(xì)胞,將其定向誘導(dǎo)分化為所需的細(xì)胞類型,再將其注入到衰老的組織中,以達(dá)到修復(fù)受損細(xì)胞、提高組織功能的目的。干細(xì)胞具有強(qiáng)大的自我更新能力和多能分化潛能,因此,在抗衰老方面具有很大的潛力。
二、要幾針才有效?
關(guān)于干細(xì)胞抗衰老的治療次數(shù),這取決于個體的年齡、身體狀況、衰老程度以及治療目的。一般來說,以下因素會影響干細(xì)胞抗衰老的治療次數(shù):
1.年齡:年齡越大,身體衰老程度越高,可能需要更多的治療次數(shù)。
2.身體狀況:身體健康狀況良好的人可能需要較少的治療次數(shù)。
3.治療目的:治療目的不同,所需的治療次數(shù)也會有所不同。例如,若是為了改善皮膚狀況,可能需要的治療次數(shù)會比改善內(nèi)臟功能要少。
通常,一個療程的治療次數(shù)為3-5次,每次間隔時間為1-3個月。然而,具體治療次數(shù)還需根據(jù)醫(yī)生的建議和患者的實際情況來確定。
三、效果能維持多久?
干細(xì)胞抗衰老的效果維持時間同樣受到多種因素的影響,包括:
1.個體差異:每個人的新陳代謝、生活習(xí)慣和遺傳因素都會影響效果的持續(xù)時間。
2.治療次數(shù):治療次數(shù)越多,效果維持的時間越長。
3.保養(yǎng)措施:治療后的保養(yǎng)措施也會影響效果的持續(xù)時間。
一般來說,干細(xì)胞抗衰老的效果可以維持1-2年,甚至更長時間。為了保持良好的效果,建議患者在治療期間和治療后積極調(diào)整生活方式,如保持良好的作息習(xí)慣、合理飲食、適當(dāng)鍛煉等。
四、總結(jié)
干細(xì)胞抗衰老技術(shù)為延緩衰老提供了一種新的途徑。要實現(xiàn)理想的效果,患者需根據(jù)自身情況選擇合適的治療次數(shù),并在治療后積極調(diào)整生活方式。雖然干細(xì)胞抗衰老的效果持續(xù)時間因人而異,但只要堅持治療和保養(yǎng),就能在很大程度上改善生活質(zhì)量,延長青春時光。在考慮接受干細(xì)胞抗衰老治療前,請務(wù)必咨詢專業(yè)醫(yī)生,以獲取個性化的建議和治療方案。
- 2024-10-14日本干細(xì)胞抗衰老技術(shù)如何操作?其效果真的有效嗎?
- 2024-08-14干細(xì)胞抗衰老持續(xù)效果怎么樣
- 2024-07-19干細(xì)胞填充法令紋,干細(xì)胞填充法令紋后注意事項
- 2024-09-06冰活體抗衰干細(xì)胞是什么,冰活體干細(xì)胞美容靠譜嗎
- 2024-09-17日本干細(xì)胞祛斑效果好嗎,干細(xì)胞祛斑原理詳解
- 2024-08-03自體干細(xì)胞抗衰,自體干細(xì)胞抗衰的優(yōu)缺點
- 2024-08-07干細(xì)胞生發(fā)技術(shù),干細(xì)胞生發(fā)技術(shù)成熟嗎
- 2024-07-21干細(xì)胞填充面部安全嗎,干細(xì)胞填充面部能維持多長時間
- 2024-08-27干細(xì)胞除皺費(fèi)用,影響費(fèi)用的因素有哪些
- 2024-09-05石家莊干細(xì)胞機(jī)構(gòu)排名榜單最新
- 2024-09-05新冠肺炎的干細(xì)胞治療方法有哪些
- 2024-08-21干細(xì)胞療法高血脂能治好嗎,治療原理及效果介紹
- 2024-08-21干細(xì)胞療法高血脂能治好嗎,治療原理及效果介紹
- 2024-09-01造血干細(xì)胞存儲價格與條件
- 2024-10-08鹽城干細(xì)胞價格是多少?與效果有何關(guān)聯(lián)?
- 2024-09-16造血干細(xì)胞捐獻(xiàn)對身體有影響嗎
- 2024-09-10干細(xì)胞做幾次達(dá)到效果,做一次能保持多久
- 2024-10-04干細(xì)胞與免疫細(xì)胞作用揭秘,它們?nèi)绾螀f(xié)同工作
